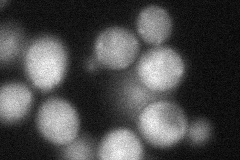
YMR237W

View description
Member of the ChAPs family (Chs5p-Arf1p-binding proteins: Bch1p, Bch2p, Bud7p, Chs6p), that forms the exomer complex with Chs5p to mediate export of specific cargo proteins from the Golgi to the plasma membrane; may interact with ribosomes
Localization:
Intensity:
Fold change:
Significance:
-
C’ GFP library in SD

punctate46.06 -
N' NOP1pr-GFP in SD

punctate154.806 -
N' TEF2pr-mCherry in SD

cytosol,punctate210.369 -
N' NATIVEpr-GFP in SD

punctate56.0088 -
N' TEF2pr-VC and Cyto-VN in SD
cytosol,punctate61.3306 -
C’ GFP library in SD+DTT

punctate55.761.21No -
C’ GFP library in SD+H2O2

punctate49.481.07No -
C’ GFP library in Starvation Media

punctate53.441.15No -
C’ GFP library on the background of Pup2-DaMP

punctate -
C’ GFP library on the background of CCT mutant

punctate52.77051.14536No
